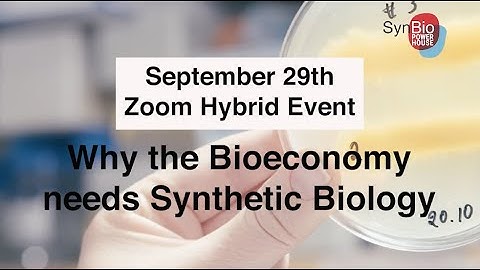
Annual seminar (full 2,5 hours): Why the Bioeconomy needs Synthetic Biology

⬇ DOWNLOAD NOW
Kalau muncul iklan pop-up, tutup lalu klik tombol kembali
Download lagu SynBioBeta Live — Optimize Your Workflow: Bottlenecks & Solutions In The Design, Build, & Test Phase secara gratis hanya untuk keperluan promosi. Dukung artis favorit kamu dengan membeli musik original di iTunes atau platform resmi lainnya.
 Natural vs Synthetic Biomaterials - What You Need to Know (7 Minutes)
Natural vs Synthetic Biomaterials - What You Need to Know (7 Minutes)
 SynBio for Human Health: Making Biology Easier to Engineer with Jason Kelly at SynBioBeta 2023
SynBio for Human Health: Making Biology Easier to Engineer with Jason Kelly at SynBioBeta 2023
 Software for Synthetic Biology Workflows: How to Improve Your Productivity and Impact | SEED 2021
Software for Synthetic Biology Workflows: How to Improve Your Productivity and Impact | SEED 2021
 Synthetic biology – the transformational technology of the 21st century
Synthetic biology – the transformational technology of the 21st century
 Streamlining Cell Line Development for Faster Biologics Production
Streamlining Cell Line Development for Faster Biologics Production
Annual seminar (full 2,5 hours): Why the Bioeconomy needs Synthetic Biology
Annual seminar (full 2,5 hours): Why the Bioeconomy needs Synthetic Biology
 Simply Synbio: What is Synthetic Biology?
Simply Synbio: What is Synthetic Biology?
 What is Synthetic Biology?
What is Synthetic Biology?